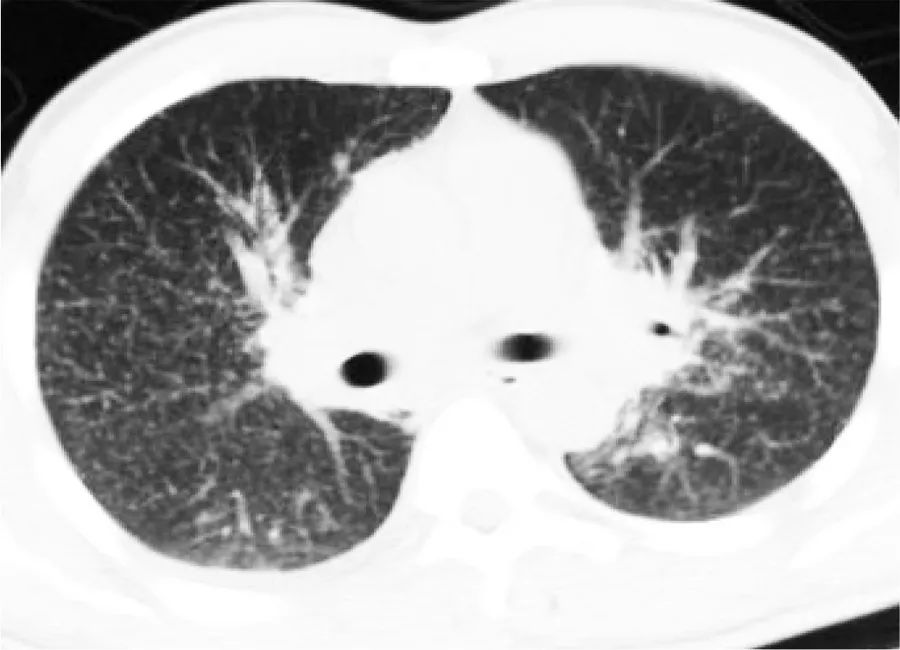
粟粒状肺结核肺部ct表现,粟粒型肺结核ct图

病例介绍
患者性别:男
患者年龄:56岁
简要病史:
因疲劳2个月,体重减轻10kg,盗汗和发热而被送急诊。
咳嗽咳痰,偶尔有血丝。
体格检查:
T 36.2℃,P 76次/min,R 18次/min,BP 115/80mmHg。
心肺听诊未及异常。
有恶病质。
辅助检查:
眼底镜显示双眼后极有多形性黄色病灶,边界不清。
X胸胸片显示广泛分布的均匀大小的结节遍布两个肺野,提示粟粒性肺结核。

胸部CT:粟粒性肺结核
支气管镜所见
支气管黏膜粟粒性结核

病理活检:肉芽肿形成

痰标本涂片呈抗酸杆菌阳性。
临床诊断:
血行播散性肺结核(急性 )
治疗经过:
利福平、异烟肼、吡嗪酰胺和乙胺丁醇的联合治疗。
治疗1周后,一个反复痰标本的抗酸杆菌涂片阴性。
6周后从初始痰标本中培养出泛敏感结核分枝杆菌。
开始治疗后,症状有所改善,完成了6个月的治疗。
复查支气管内镜,病变消失。

=====
附件
肺结核诊断标准国家标准 WS288-2017



既往笔记
淋巴结肿大|紫癜(结核性淋巴结炎)
儿童尺骨结核
25918882